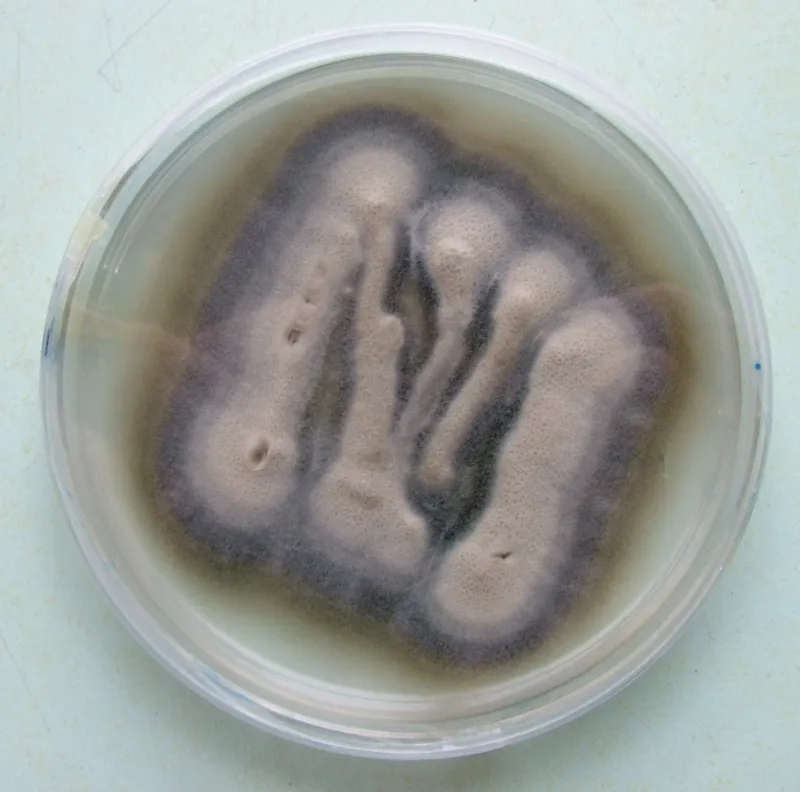
Plaga de VERTICILOSIS, VERTICILLIUM DAHLIAE

Plaga
VACANITA DEL MELONAR, EPILACHNA CHRYSOMELINA
1 cultivo relacionado

1920 formulados registrados · 1432 con autorizaciones vigentes
LISTADO A-Z

Plaga
1 cultivo relacionado
Plaga
4 cultivos relacionados

Plaga
3 cultivos relacionados

Plaga
19 cultivos relacionados
Plaga
5 cultivos relacionados

Plaga
3 cultivos relacionados
Plaga
4 cultivos relacionados

Plaga
6 cultivos relacionados

Plaga
14 cultivos relacionados
Plaga
1 cultivo relacionado
Plaga
3 cultivos relacionados
En la última actualización añadimos las siguientes entradas a la base de datos.
Producto
PIRETRINAS 5% [RB] P/P · RB
ECOLOGIA Y PROTECCIÓN AGRÍCOLA, S.L.
Producto
IODOSULFURON-METIL-SODIO 5% [WG] P/P · WG
SHARDA CROPCHEM ESPAÑA S.L.
Producto
DIFENOCONAZOL 25% [EC] P/V · EC
INDOFIL INDUSTRIES (NETHERLANDS) B.V.
Producto
ACIDO PELARGÓNICO 58,02 % [EC] P/V · EC
COMPO IBERIA, S.L.